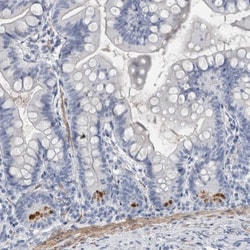
Invitrogen Lplunc1 Polyclonal Antibody 100 &mu;L; Unconjugated:Antibodies,

Promotional price valid on web orders only. Your contract pricing may differ. Interested in signing up for a dedicated account number?
Learn More
Learn More
Invitrogen™ Lplunc1 Polyclonal Antibody


Rabbit Polyclonal Antibody
Supplier: Invitrogen™ PA555030
Description
Immunogen sequence: PKVIKEKLTQ ELKDHNATSI LQQLPLLSAM REKPAGGIPV LGSLVNTVLK HIIWLKVITA NILQLQVKPS ANDQELLVKI PLDMVAGFNT PLVKTIVEFH MTTEAQATIR MDTSASGPTR LVLSDCATSH Highest antigen sequence identity to the following orthologs: Mouse - 65%, Rat - 64%.
The protein encoded by this gene may be involved in the innate immune response to bacterial exposure in the mouth, nasal cavities, and lungs. The encoded protein is secreted and is a member of the BPI/LBP/PLUNC protein superfamily. This gene is found with other members of the superfamily in a cluster on chromosome 20.
Specifications
| Lplunc1 | |
| Polyclonal | |
| Unconjugated | |
| BPIFB1 | |
| BPI fold containing family B member 1; BPI fold containing family B, member 1; BPI fold-containing family B member 1; BPIFB1; C20orf114; long palate, lung and nasal epithelium carcinoma associated 1; long palate, lung and nasal epithelium carcinoma-associated protein 1; Lplunc1; UNQ706/PRO1357; VEMSGP; von Ebner minor salivary gland protein; von Ebner minor salivary protein | |
| Rabbit | |
| Antigen affinity chromatography | |
| RUO | |
| 92747 | |
| Store at 4°C short term. For long term storage, store at -20°C, avoiding freeze/thaw cycles. | |
| Liquid |
| Immunohistochemistry (Paraffin) | |
| 0.05 mg/mL | |
| PBS with 40% glycerol and 0.02% sodium azide; pH 7.2 | |
| Q8TDL5 | |
| BPIFB1 | |
| Recombinant protein corresponding to Human Lplunc1. Recombinant protein control fragment (Product #RP-90189). | |
| 100 μL | |
| Primary | |
| Human | |
| Antibody | |
| IgG |
Product Content Correction
Your input is important to us. Please complete this form to provide feedback related to the content on this product.
Product Title
Spot an opportunity for improvement?Share a Content Correction